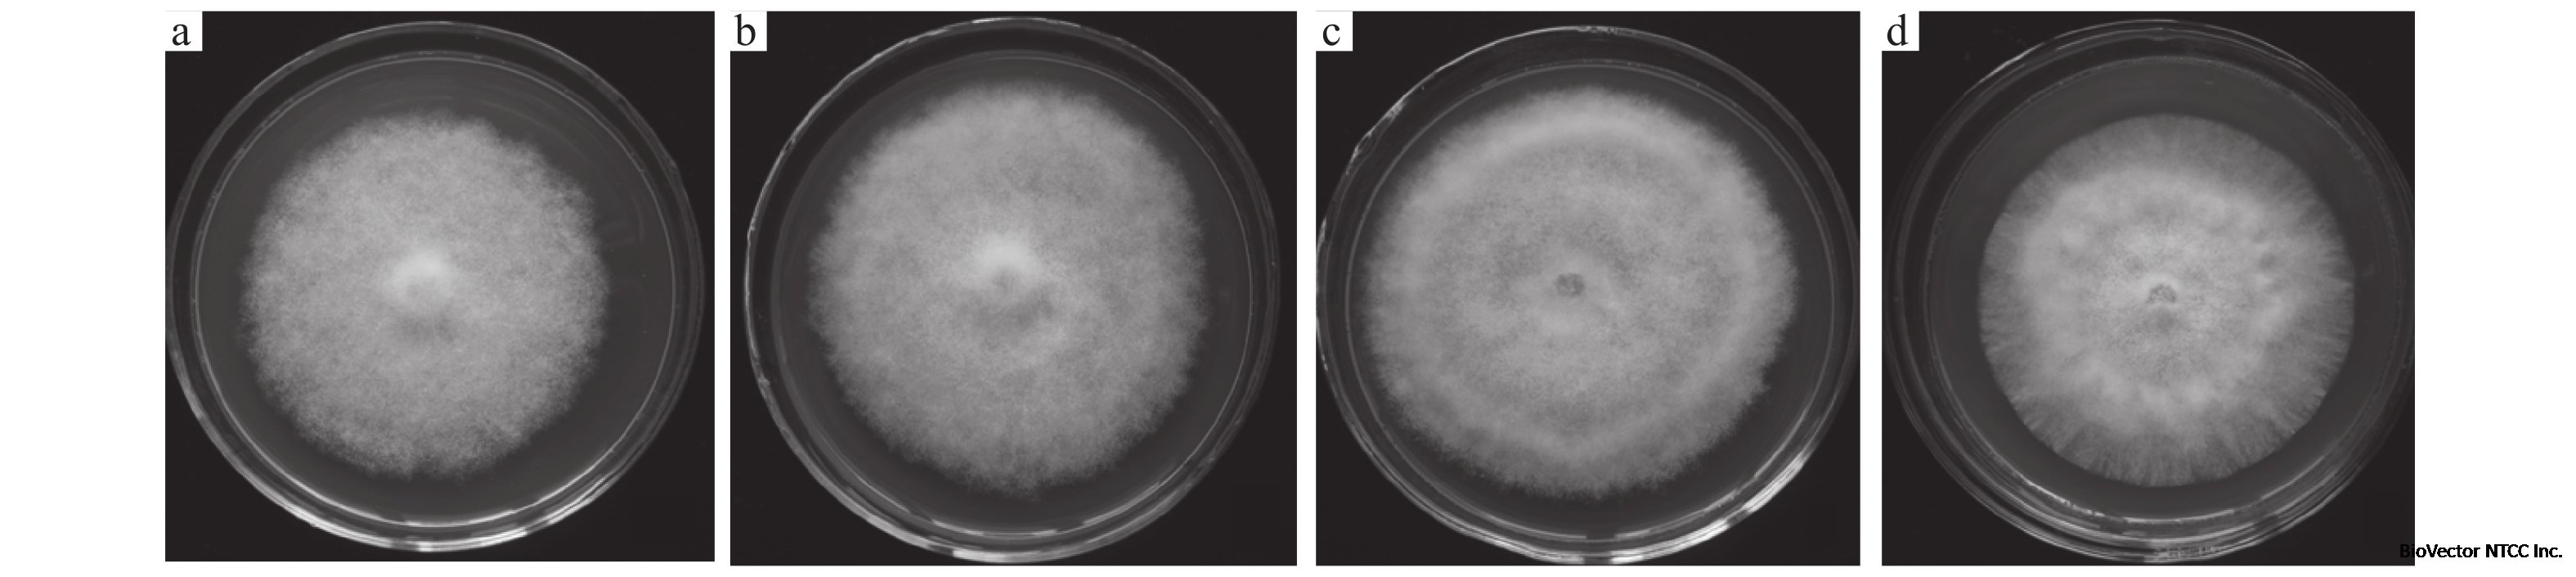
荔枝果皮多酚对荔枝霜疫霉生物学特性的影响

Peronophythora litchii BioVector®荔枝霜疫霉菌 / Litchi Downy Blight Fungus -BioVector NTCC典型培养物保藏中心
- 价 格:¥599850
- 货 号:BioVector® Peronophythora litchii
- 产 地:北京
- BioVector NTCC典型培养物保藏中心
- 联系人:Dr.Xu, Biovector NTCC Inc.
电话:400-800-2947 工作微信:1843439339 (QQ同号)
邮件:Biovector@163.com
手机:18901268599
地址:北京
- 已注册
BioVector® Peronophythora litchii 荔枝霜疫霉菌 / Litchi Downy Blight Fungus 数据说明书
产品名称: BioVector® Peronophythora litchii 菌种
中文名称: BioVector® 荔枝霜疫霉菌
英文名称: BioVector® Peronophythora litchii (Litchi Downy Blight Fungus)
产品类别: 植物病原真菌
菌种类型: 卵菌 (Oomycete)
分类地位: 鞭毛菌亚门,卵菌纲,霜霉目,霜疫霉科 (Peronophythoraceae) -4
拉丁学名: Peronophythora litchii Chen ex Ko et al. -1-10
同义词: 荔枝霜霉病菌、荔枝疫病菌 -1
分离来源: 分离自荔枝果实/果皮 -3-10
主要用途: 植物病害研究;荔枝霜疫霉病病原菌鉴定;杀菌剂筛选;植物-病原互作研究 -3-10
形态特征:
生长温度范围:11-33℃,最适生长温度:22-25℃ -4
孢子囊形成最适温度:22-25℃ -4
孢子囊萌发:8-22℃形成游动孢子,26-30℃直接萌发成芽管 -4
需氧类型:好氧 -3
对湿度要求高,高湿条件下致病性强 -4
寄主范围: 主要侵染荔枝,亦可侵染番木瓜;人工接种可侵染番茄和丝瓜果实 -4
培养基: BioVector® PDA 培养基(马铃薯葡萄糖琼脂培养基)-3-8
培养基配方: 马铃薯提取液 1.0L,葡萄糖 20.0g,琼脂 15.0g,pH自然 -3
培养温度: 25-28°C -3-8
保存方法: 4-10°C冷藏保存(短期);液氮超低温冷冻保存(长期)-3-5
冻存保护剂: 10%甘油 或 5-15% DMSO -5
冻存方法: 缓慢降温(1°C/min至-40°C)后转入液氮保存 -5
复苏方法: 38°C水浴快速解冻 -5
产品形式: 冻干粉 / 斜面培养物 / 甘油菌 -3-8
生物安全等级: 1 -10
质量控制: 无菌检测:阴性;活力检测:复苏后生长良好;形态学鉴定:符合标准描述
储存与运输: 4-10°C冷藏运输(短期),干冰或液氮运输(长期)
仅供科研使用
English:
BioVector® Peronophythora litchii (Litchi Downy Blight Fungus) Datasheet
Product Name: BioVector® Peronophythora litchii Strain
Chinese Name: BioVector® 荔枝霜疫霉菌
English Name: BioVector® Peronophythora litchii (Litchi Downy Blight Fungus)
Product Category: Plant Pathogenic Fungus
Strain Type: Oomycete
Taxonomic Classification: Mastigomycotina, Oomycetes, Peronosporales, Peronophythoraceae -4
Scientific Name: Peronophythora litchii Chen ex Ko et al. -1-10
Synonyms: Litchi downy blight fungus -1
Isolation Source: Isolated from litchi fruit/pericarp -3-10
Primary Applications: Plant pathology research; Identification of litchi downy blight pathogen; Fungicide screening; Plant-pathogen interaction studies -3-10
Morphological Characteristics:
Colony Morphology: Whitish cream colonies on PDA medium -9
Asexual Stage: Sporangiophores are tree-like, asymmetrically branched, colorless, with multiple septa; sporangia are colorless to light brown, lemon-shaped or long ellipsoid, with apical papillae -1-4
Sexual Stage: Produces oospores, spherical, colorless to light yellow, smooth-walled -1-4
Biological Characteristics:
Temperature Range for Growth: 11-33°C, Optimal Growth Temperature: 22-25°C -4
Optimal Temperature for Sporangia Formation: 22-25°C -4
Sporangia Germination: 8-22°C (zoospore formation), 26-30°C (direct germination into germ tubes) -4
Oxygen Requirement: Aerobic -3
Requires high humidity for infection -4
Host Range: Mainly infects litchi; can also infect papaya; under artificial inoculation, can infect tomato and loofah fruits -4
Culture Medium: BioVector® PDA Medium (Potato Dextrose Agar) -3-8
Medium Composition: Potato extract 1.0L, glucose 20.0g, agar 15.0g, natural pH -3
Culture Temperature: 25-28°C -3-8
Storage Methods: 4-10°C refrigeration (short-term); Liquid nitrogen ultra-low temperature freezing (long-term) -3-5
Cryoprotectant: 10% glycerol or 5-15% DMSO -5
Freezing Method: Slow cooling (1°C/min to -40°C) followed by transfer to liquid nitrogen -5
Thawing Method: Rapid thawing in 38°C water bath -5
Product Format: Freeze-dried powder / Slant culture / Glycerol stock -3-8
Biosafety Level: 1 -10
Quality Control: Sterility Test: Negative; Viability Test: Good growth upon revival; Morphological Identification: Conforms to standard description
Storage and Shipment: Refrigerated transport at 4-10°C (short-term), dry ice or liquid nitrogen transport (long-term)
For Research Use Only
BioVector NTCC质粒载体菌株细胞蛋白抗体基因保藏中心
电话:400-800-2947
工作QQ/微信同号:1843439339
网址http://www.biovector.net
- 公告/新闻
-
-



